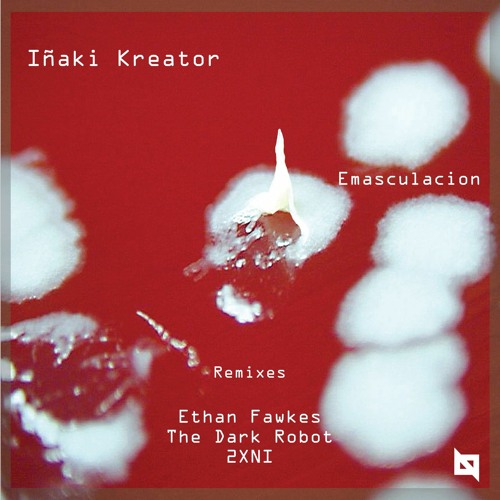

Inaki Kreator - Emasculación (The Dark Robot vocal remix) Nu Body Records
The Dark Robot
386
5:33
Apr 20, 2020
20
2
1
Remix, lyrics and vocal by The Dark Robot
Available on Nu Body Records :
www.beatport.com/release/emasculacion/2893998
or
nubodyrecords.bandcamp.com/track/inaki…robot-remix
Youtube :
youtu.be/8mKT9A07LPU





![PREMIERE | 𝐍𝐨𝐭𝐚𝐮𝐬𝐠𝐚𝐧𝐠 - 𝐓𝐡𝐞 𝐈𝐧𝐯𝐢𝐬𝐢𝐛𝐥𝐞 𝐇𝐚𝐧𝐝 [𝐑𝐏𝐓𝟎𝟎𝟐]](https://i1.sndcdn.com/artworks-kOBgUI2sW4SjZnBd-0zoqNQ-t240x240.jpg)

